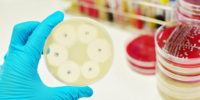

In recent years, major news outlets have started taking note of the animal movement, and including coverage of animal rights, welfare, and conservation issues on a daily basis. Check out our curated selection of top stories from around the world, updated every day.
___
-
Animal People, Inc. posted an update 9 years, 2 months ago‘No alternatives to antibiotics’ warns expertLeading food scientist Johanna Fink-Gremmels has warned that if meat-producing livestock is infected with a disease and requires treatment there are “no alternatives to antibiotics”.
-
Animal People, Inc. posted an update 9 years, 2 months ago
http://www.care2.com/causes/first-oryx-calf-born-in-the-wild-in-30-years.html
First Oryx Calf Born In The Wild In 30 Years | Care2 CausesConservationists are celebrating the birth of a rare Scimitar-horned oryx in Chad, who is the first calf to be born in the wild in 30 years.
-
Animal People, Inc. posted an update 9 years, 2 months agoHundreds of snow leopards being killed every year, report warnsFigure of 220-450 annual deaths could be even higher, as killings by poachers or farmers often go undetected in the remote mountains of central Asia
-
Animal People, Inc. posted an update 9 years, 2 months agoWorld's mammals being eaten into extinction, report warnsFirst global assessment finds 301 species are primarily at risk from human hunting for the bushmeat trade
-
Animal People, Inc. posted an update 9 years, 2 months agoJapan to face criticism at international summit for flouting whaling rulingJapanese fleets have killed more than 300 minke whales in the Southern Ocean despite a court ruling and three-decade-old ban
-
Animal People, Inc. posted an update 9 years, 2 months agoRare birds thriving on Scilly Isles after scheme rids islands of ratsNumber of nesting Manx shearwaters almost triples in three years after a project, backed by Prince Chales, sucessfully kills off the rats that eat the birds’ chicks and eggs
-
Animal People, Inc. posted an update 9 years, 2 months agoScientists investigate death of 10,000 endangered 'scrotum' frogs in PeruResearchers and campaingers suspect pollution killed the rare Titicaca water frogs that are endemic to the famous lake and derive their nickname from their wrinkly skin
-
Animal People, Inc. posted an update 9 years, 2 months agoTasmanian devils developing immune response to contagious face cancerBreakthrough the first indication the tumour is survivable and confirms research showing marsupials are rapidly evolving in response to the disease
-
Animal People, Inc. posted an update 9 years, 2 months agoSpiders can 'tune' their webs to sound out plucky potential matesSpiders can control their web’s tension and stiffness to help them identify potential partners as well as prey, study shows
-
Animal People, Inc. posted an update 9 years, 2 months agoThe week in wildlife – in picturesAn inquisitive polar bear, blue-footed boobies and autumn colours are among this week’s pick of images from the natural world
-
Animal People, Inc. posted an update 9 years, 2 months agoPark ranger murdered while trying to protect Congo's rare gorillasMunganga Nzonga Jacques died in a region of Kahuzi Biega national park previously believed to be safe for the gorillas, Mongabay reports
-
Animal People, Inc. posted an update 9 years, 2 months agoClimate change impairs survival instincts of fish and can make them swim towards predatorsFish farms may hold the key to studying the impact of rising carbon dioxide on marine life, and help researchers understand if fish could adapt to climate change.
-
Animal People, Inc. posted an update 9 years, 2 months agoSnow Leopards Could Lose Two Thirds of Their Habitat Due to Climate ChangeBut certain high-elevation refuges will remain, according to new research
-
Anita Mayangpuspa posted an update 9 years, 2 months ago
-
Animal People, Inc. posted an update 9 years, 2 months ago
http://www.allgov.com/news?news=859564
Federal Judge Shoots Down NRA Challenge to U.S. Ban on Elephant Trophy ImportsDefendant-intervenor Friends of Animals' legal director Michael Harris said,
-
Animal People, Inc. posted an update 9 years, 2 months ago
How ‘Cage-Free’ Hens Live, in Animal Advocates’ Video
-
Animal People, Inc. posted an update 9 years, 2 months ago
-
Animal People, Inc. posted an update 9 years, 2 months ago
-
Animal People, Inc. posted an update 9 years, 2 months agoThinking of giving up red meat? Half measures may end up increasing animal sufferingTo animal protection advocates, a pledge to eat less meat is good news. Even a small step like Meatless Mondays is generally better than nothing. All too often, however, aspiring ethical eaters choose a favored animal or two to exclude from their diet, without actually reducing their total animal consumption. Despite good intentions, they may end up increasing animal suffering.
-
Anita Mayangpuspa posted an update 9 years, 2 months agoDog nailed in the HEAD and buried ALIVE: One of RSPCA's worst animal cruelty casesTHIS shocking x-ray reveals one of the worst animal cruelty cases ever seen by the RSPCA – a dog buried alive with a nail hammered into his head.